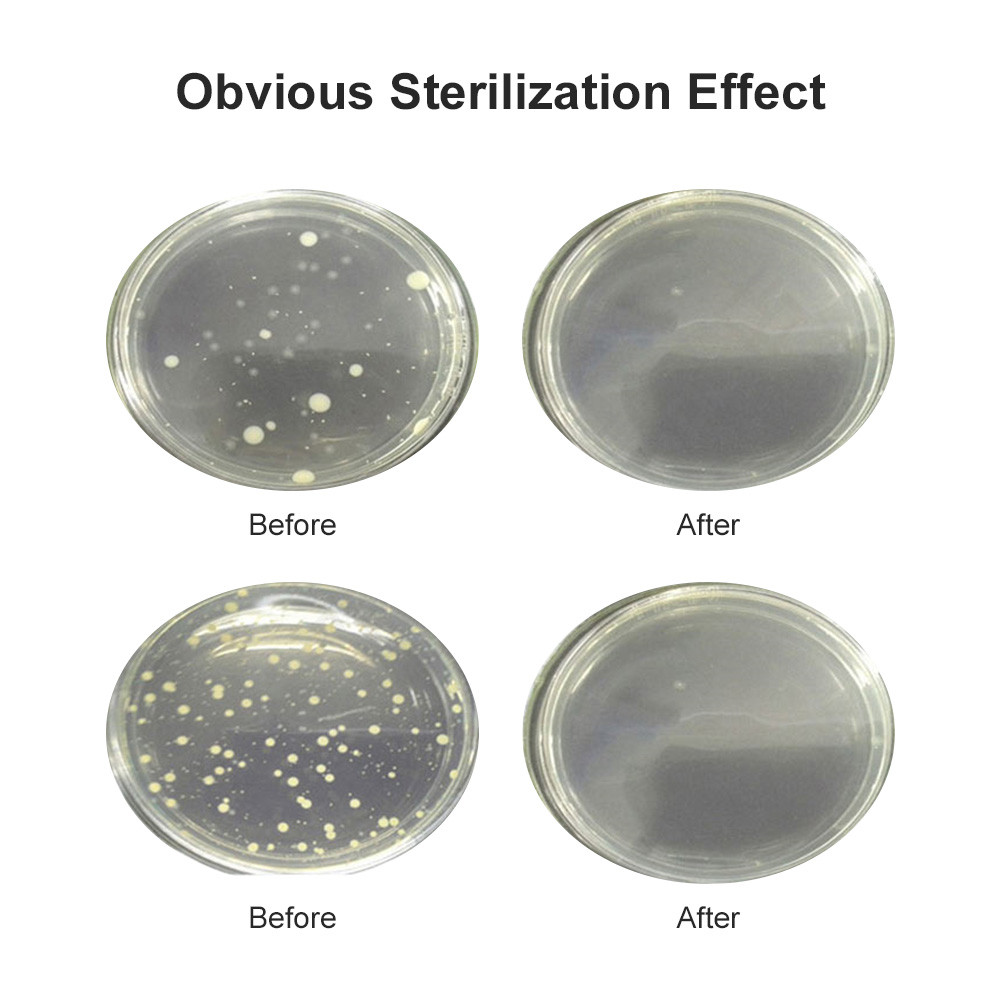

1/10
After Voucher
JBMBHC CPAP Cleaner & Disinfectant Generator Cleaner Air Disinfectant Machine CPAP Mask Cleaner for CPAP Machine
Guaranteed to get by 9 Apr - 11 Apr
Free shipping
Get a $1.00 voucher if your order arrives late.
15-Day Free Returns • Extended Warranty